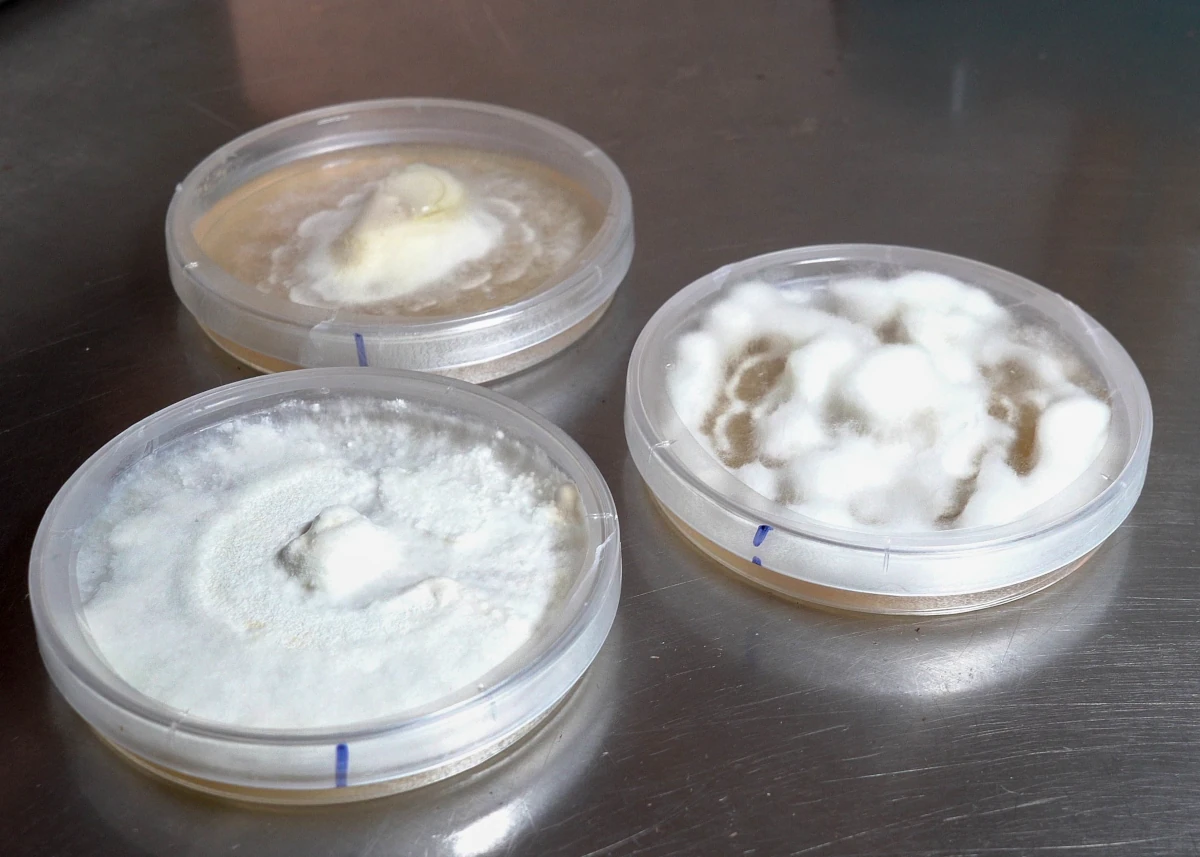
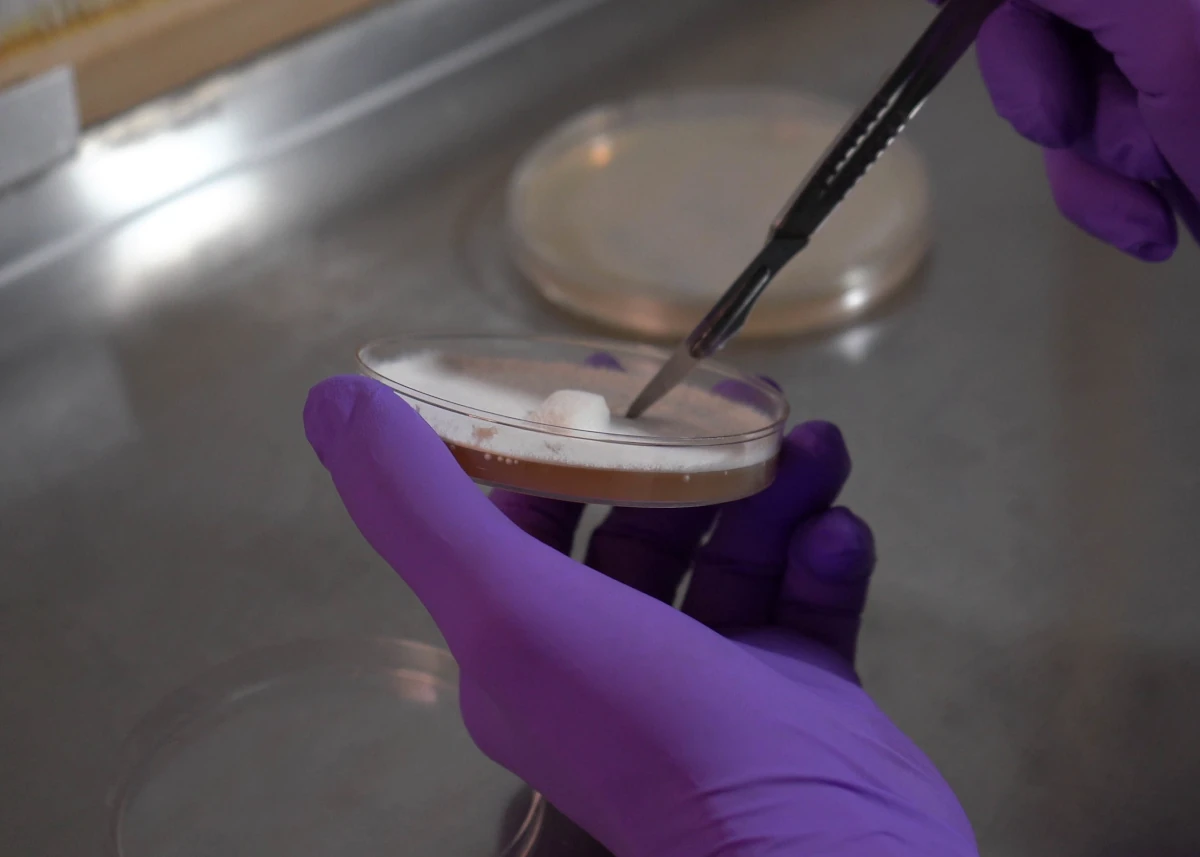

Replace Fossil-Based Plastics with Biological Materials
Mycopor develops mycelium-based protective materials designed for packaging, insulation, and industrial applications.
A natural alternative to conventional materials such as EPS and PU foam — aligned with emerging European packaging regulations.
Developed with support from research and industry partners



Material testing & certification
Material properties are currently being validated for industrial use, including compostability, mechanical performance, and insulation characteristics.
Certification according to EN 13432 is in progress.
Testing supported by Biotechnical Faculty, University of Ljubljana.
Packaging and insulation materials used today are still largely based on fossil resources.
Plastics and foam materials such as EPS and PU dominate supply chains because they are lightweight and inexpensive.
However, European regulations such as the Packaging and Packaging Waste Regulation (PPWR) are pushing companies to reduce waste and move away from fossil-based materials.
As a result, manufacturers are increasingly exploring new material alternatives.
Material performance testing includes
Density range
Thermal conductivity
Water absorption
Compression resistance
Testing and material characterization are currently being conducted to support industrial applications in packaging and construction. Testing is supported by Biotechnical Faculty, University of Ljubljana
We Grow Materials Instead of Manufacturing Them
Mycopor develops materials using mycelium, a natural biological network capable of binding organic matter into solid structures.
Agricultural byproducts form the base of the material, while mycelium grows through the structure and binds it into a lightweight bio-composite.
The result is a structured material suitable for protective packaging, insulation components, and molded industrial parts.
Our materials are designed for industrial environments where plastic and foam components are traditionally used.
Mycopor bio-composite materials are currently undergoing technical testing.
Preliminary material characteristics include:
| Density | Water absorption | Moisture storage | Thermal conductivity | Smoke emission class | Industrial compostability |
|---|---|---|---|---|---|
| 50–180 kg/m³ | 0.90–1.4 kg/m² | ~8% at 50% RH | 0.035 W/mK | B-s1-d0 | ~30 days under industrial composting conditions |
Introducing a new material into production does not need to be complex.
Most companies begin by exploring specific packaging or material components that could potentially be replaced with a bio-based alternative.
Start with a simple material evaluation
1 - Identify a component that could be replaced
2 — Develop a sample or pilot mold
3 — Test the material in real conditions
This allows companies to evaluate the material before making production changes.






Mycopor materials are designed for industrial environments where plastic and foam components are traditionally used.
Typical applications include:
Molded packaging inserts
for electronics, appliances, and fragile products
Transport protection
components used during shipping and logistics
Protective cushioning parts
for industrial and consumer products
Insulation and structural panels
for construction applications
Many companies begin by replacing one specific component before expanding to additional applications.
If your company is exploring alternatives to plastic or foam materials, Mycopor can help evaluate whether bio-based materials could work for your application.